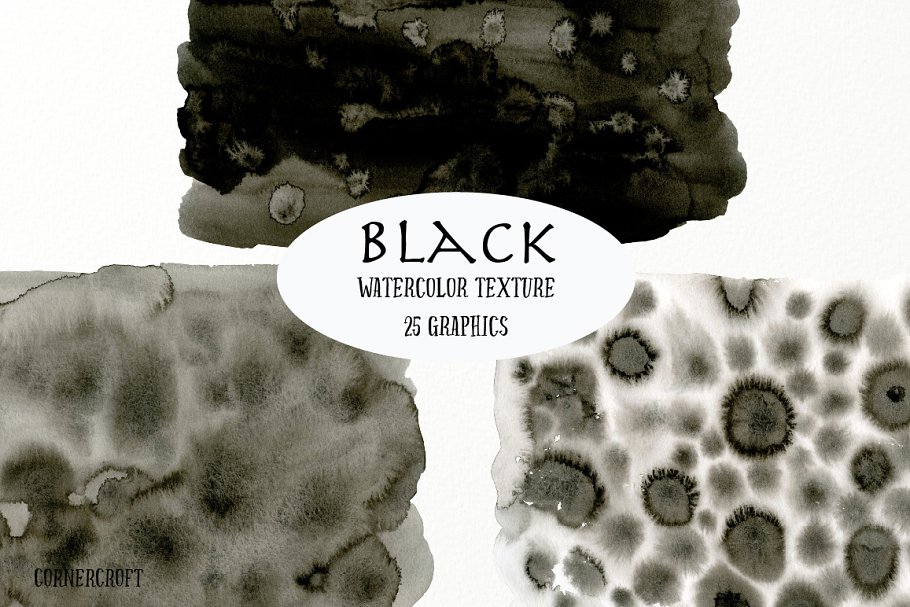
手绘水彩画墨水纹理 Watercolor Texture Black插图(4)

手绘水彩画墨水纹理 Watercolor Texture Black
会员
这组合集包括了手绘水彩黑墨纹理,包含14个长方形和11个笔刷。可用于背景婚礼请柬,聚会请柬和万圣节等其他更多设计项目。
素材特点:
- 14个水彩矩形,png,一般为7英寸x 14英寸,300dpi
- 11个水彩笔画,png,通常10英寸长,宽度不一





温馨提示:本资源来源于互联网,仅供参考学习使用。若该资源侵犯了您的权益,请 联系我们 处理。
猜你喜欢
扫描二维码用手机观看
推荐素材
这组合集包括了手绘水彩黑墨纹理,包含14个长方形和11个笔刷。可用于背景婚礼请柬,聚会请柬和万圣节等其他更多设计项目。
素材特点: